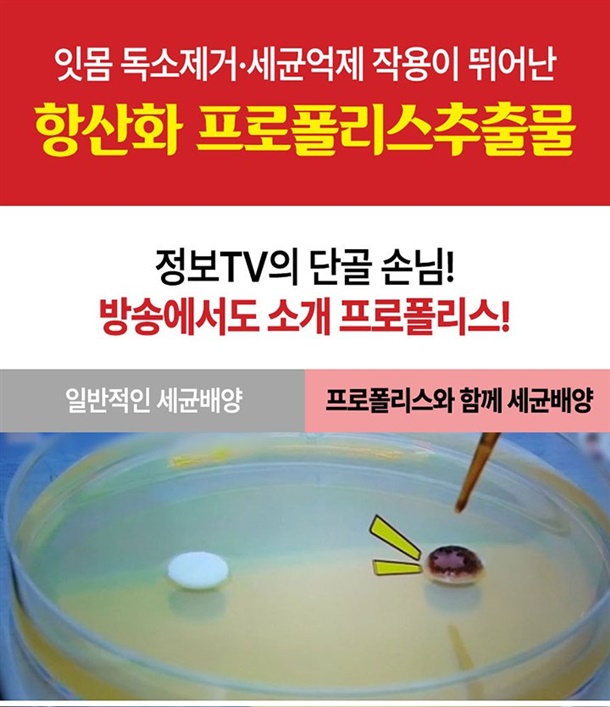

친구 초대 리워드
친구와 함께 쇼핑도 즐기고 포인트도 받자!
다양한 공유 방법으로 친구를 초대하고 함께 혜택을 받으세요!
 STEP.1
STEP.1
- 친구 초대 리워드 URL 공유하기
- 친구나 지인에게 리워드 URL을 복사해서 공유하세요.
 STEP.2
STEP.2
- 친구 또는 지인이 링크를 클릭하고 회원가입
- 반드시 리워드 URL로 친구나 지인이 가입하셔야 합니다.
 STEP.3
STEP.3
- 회원가입이 완료되면 포인트 적립
- 동일한 방법으로 다른 친구나 지인이 회원가입을 하면 혜택을 받을 수 있습니다.
혜택_친구가 회원가입을 하고 첫 구매를 할 경우
· 나의 포인트 적립 0p, 친구는 0p 적립
기타 안내
· 친구 초대 리워드 혜택은 회원에게만 제공됩니다.
· 회원가입 리워드 포인트는 즉시 지급되며 첫 구매 혜택은 상품 배송 완료 후 1일 후에 적립됩니다.
· 적립 내역은 마이페이지 > 포인트 적립 내역에서 확인해 주세요.

구매
구매
 카카오로 1초 간편 로그인!
카카오로 1초 간편 로그인!
#answer_name# #answer_regdate#